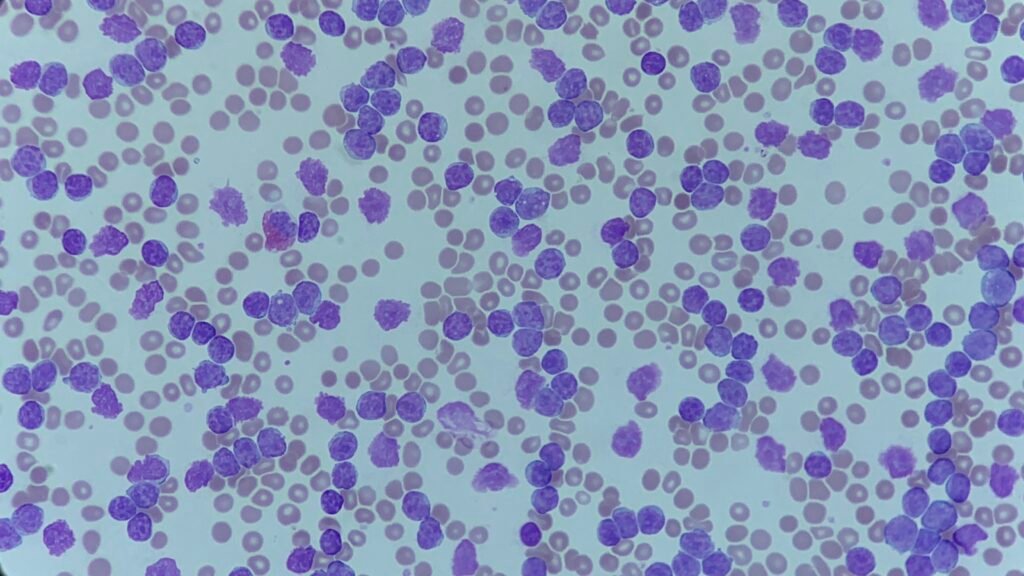
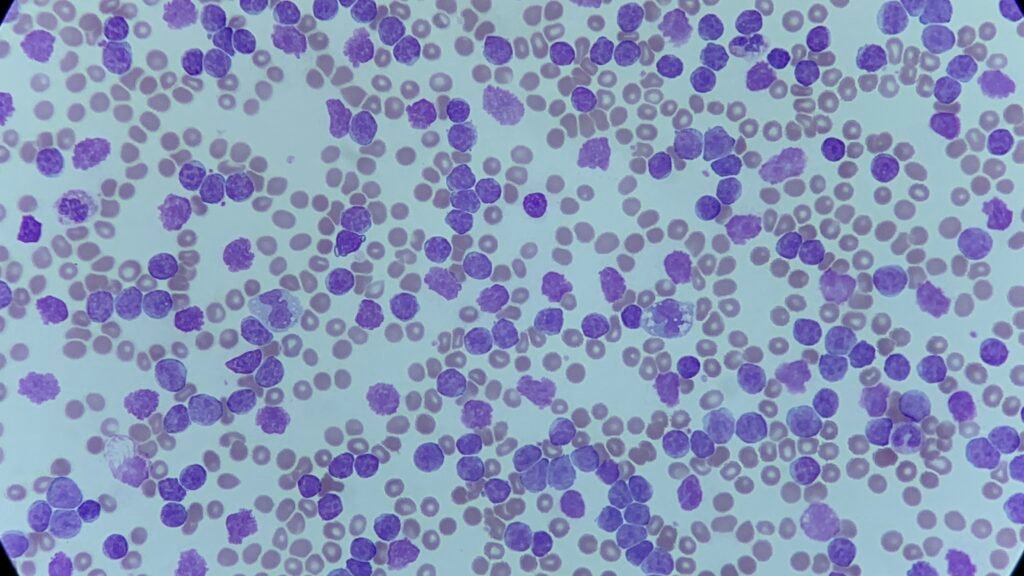

This week’s case featured an 84-year-old male referred after routine blood tests showed an extremely elevated white cell count. He reported increasing fatigue but no other significant symptoms.
Summary of key findings:
- WBC: 823 ×10⁹/L
- Exceeded analyser linearity → dilution required for accurate quantitation
- RBC: 2.69 ×10¹²/L
- Hb: 84–106 g/L (corrected for WBC interference)
- Platelets: 164 ×10⁹/L

Blood film features:
- A pleomorphic population of lymphocytes
- Small to medium-sized cells with a high nuclear-cytoplasmic ratio
- Clumped (“soccer-ball”) chromatin
- Occasional prolymphocytes
- Presence of smear cells
These features are classical for CLL. The combination of a markedly elevated lymphocyte count, characteristic morphology, and a supporting clinical picture strongly points to chronic lymphocytic leukaemia as the final diagnosis.
Dealing with results outside the analyser linearity range:
This case also raised an interesting challenge from an analytical perspective. How do we deal with results that are outside the linearity range of an analyser? Best practice includes:
- Performing a manual or automated dilution of the sample using the analyser’s recommended protocol
- Repeating the test on the diluted specimen to obtain a reliable, linear result (remember to multiply the diluted result by the dilution factor to get the actual result!)
- Documenting the action including the dilution factor
- Correcting impacted parameters, such as haemoglobin (WBC interference), if required
- Reviewing histograms/scatterplots for flagging patterns that may require additional checks